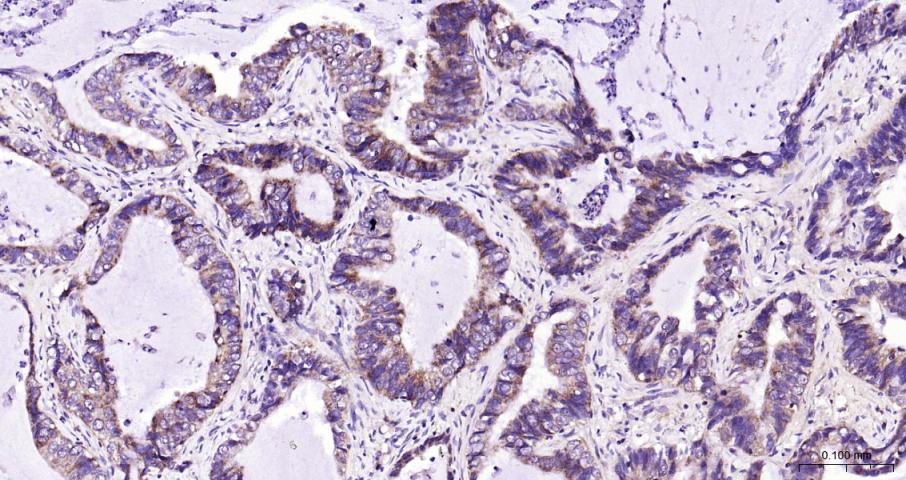
Bcl-xL蛋白抗体-bs-25848R
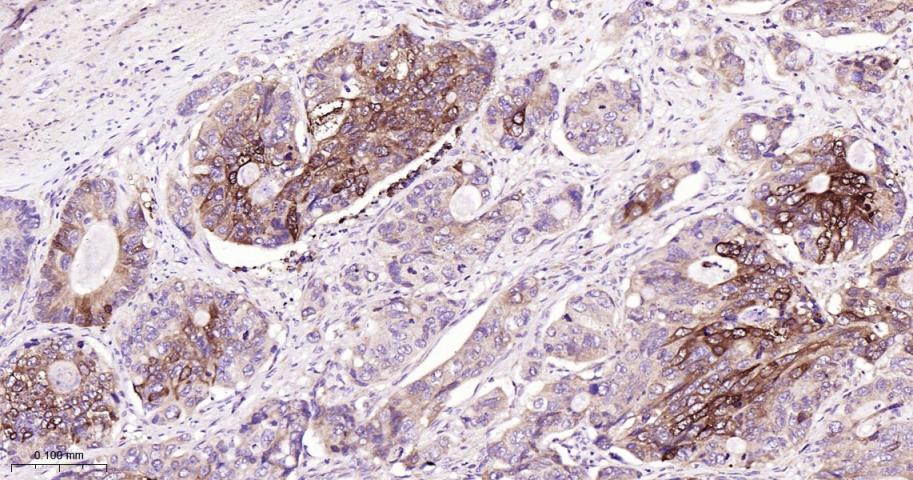
Bcl-xL蛋白抗体-bs-25848R

Bcl-xL Rabbit pAb (一抗) - IHC-P,IHC-F,IF | Bioss

货号:bs-25848R
产品详情
相关标记
相关产品
相关文献
常见问题
概述
产品编号
bs-25848R
英文名称
Bcl-xL Rabbit pAb
中文名称
Bcl-xL蛋白抗体
英文别名
BCL-XL/S; BCL2L; BCLX; Bcl-X; PPP1R52; Bcl(X)L; Bcl-XL; bcl2-L-1; B2CL1_HUMAN; BCL2L1; Apoptosis regulator Bcl-X; B2CL1_MOUSE; B2CL1_RAT; Blc2l; BCL2 like 1; protein phosphatase 1, regulatory subunit 52
抗体来源
Rabbit
免疫原
KLH conjugated synthetic peptide derived from the human Bcl-xL: 21-120/233
亚型
IgG
性状
Liquid
纯化方法
affinity purified by Protein A
克隆类型
Polyclonal
理论分子量
26 kDa
浓度
1mg/ml
储存液
0.01M TBS (pH7.4) with 1% BSA, 0.02% Proclin300 and 50% Glycerol.
研究领域
Cancer > Cancer Metabolism > Response to hypoxia
Cancer > Cell Death > Apoptosis > Apoptosis Markers > Bcl 2 family
Cancer > Cell Death > Apoptosis > Metabolism
Cancer > Invasion/microenvironment > Apoptosis > Bcl 2 family
Cancer > Oncoproteins/suppressors > Oncoproteins > Cell survival & death
Cancer > Tumor biomarkers > Oncoproteins
Cell Biology > Apoptosis > Intracellular > Bcl2 Family
Metabolism > Pathways and Processes > Metabolism processes > Apoptosis
Metabolism > Pathways and Processes > Metabolism processes > Hypoxia
Metabolism > Pathways and Processes > Mitochondrial Metabolism > Mitochondrial markers
SWISS
Gene ID
保存条件
Shipped at 4℃. Store at -20℃ for one year. Avoid repeated freeze/thaw cycles.
数据库链接
产品介绍
Bcl X/L蛋白是Bcl蛋白家族的成员之一,是细胞中抑制细胞凋亡的重要分子之一,Bcl-X/L是结构上与Bcl-2具有43%同源性的蛋白,与Bcl-2的作用相同,可抑制细胞凋亡,在肿瘤的发生和发展中起重要作用。
背景资料
bs-1336P is one synthetic peptide derived from human Bcl-xL.
The protein encoded by this gene belongs to the BCL-2 protein family. BCL-2 family members form hetero- or homodimers and act as anti- or pro-apoptotic regulators that are involved in a wide variety of cellular activities. The proteins encoded by this gene are located at the outer mitochondrial membrane, and have been shown to regulate outer mitochondrial membrane channel (VDAC) opening. VDAC regulates mitochondrial membrane potential, and thus controls the production of reactive oxygen species and release of cytochrome C by mitochondria, both of which are the potent inducers of cell apoptosis. Two alternatively spliced transcript variants, which encode distinct isoforms, have been reported. The longer isoform acts as an apoptotic inhibitor and the shorter form acts as an apoptotic activator. [provided by RefSeq, Jul 2008].
The protein encoded by this gene belongs to the BCL-2 protein family. BCL-2 family members form hetero- or homodimers and act as anti- or pro-apoptotic regulators that are involved in a wide variety of cellular activities. The proteins encoded by this gene are located at the outer mitochondrial membrane, and have been shown to regulate outer mitochondrial membrane channel (VDAC) opening. VDAC regulates mitochondrial membrane potential, and thus controls the production of reactive oxygen species and release of cytochrome C by mitochondria, both of which are the potent inducers of cell apoptosis. Two alternatively spliced transcript variants, which encode distinct isoforms, have been reported. The longer isoform acts as an apoptotic inhibitor and the shorter form acts as an apoptotic activator. [provided by RefSeq, Jul 2008].

产品应用
| 应用 | 已检合格种属 | 预测种属 | 推荐稀释比例 |
|---|---|---|---|
| IHC-P | Human | 1:100-500 | |
| IHC-F | Human | 1:100-500 | |
| IF | Human | 1:100-500 | |
| ELISA | Human | 1:5000-10000 |
交叉反应
交叉反应: Human
相关产品
暂无相关产品
靶标
基因名
BCL2L1
蛋白名
Bcl-2-like protein 1
亚基
Homodimer. Isoform Bcl-X(L) forms heterodimers with BAX, BAK or BCL2. Heterodimerization with BAX does not seem to be required for anti-apoptotic activity. Interacts with BCL2L11. Interacts with DMN1L; the interaction stimulates the GTPase activity of DMN1L in synapses and increases the number of axonal mitochondria and the size and number of synaptic vesicle clusters. Interacts with BAD and BBC3. Interacts (isoform Bcl-X(L)) with SIVA1 (isoform 1); the interaction inhibits the anti-apoptotic activity. Interacts with BECN1 and PGAM5. Interacts (isoform Bcl-X(L)) with BAX (isoform Sigma). Isoform Bcl-X(L) interacts with IKZF3. Interacts with HEBP2.
亚细胞定位
Mitochondrion membrane; Single-pass membrane protein. Nucleus membrane; Single-pass membrane protein; Cytoplasmic side. Cytoplasm, cytoskeleton, centrosome. Note=Mitochondrial membranes and perinuclear envelope. Localizes to the centrosome when phosphorylated at Ser-49.
组织特异性
Bcl-X(S) is expressed at high levels in cells that undergo a high rate of turnover, such as developing lymphocytes. In contrast, Bcl-X(L) is found in tissues containing long-lived postmitotic cells, such as adult brain.
翻译后修饰
Proteolytically cleaved by caspases during apoptosis. The cleaved protein, lacking the BH4 motif, has pro-apoptotic activity.
Phosphorylated on Ser-62 by CDK1. This phosphorylation is partial in normal mitotic cells, but complete in G2-arrested cells upon DNA-damage, thus promoting subsequent apoptosis probably by triggering caspases-mediated proteolysis. Phosphorylated by PLK3, leading to regulate the G2 checkpoint and progression to cytokinesis during mitosis. Phosphorylation at Ser-49 appears during the S phase and G2, disappears rapidly in early mitosis during prometaphase, metaphase and early anaphase, and re-appears during telophase and cytokinesis.
Phosphorylated on Ser-62 by CDK1. This phosphorylation is partial in normal mitotic cells, but complete in G2-arrested cells upon DNA-damage, thus promoting subsequent apoptosis probably by triggering caspases-mediated proteolysis. Phosphorylated by PLK3, leading to regulate the G2 checkpoint and progression to cytokinesis during mitosis. Phosphorylation at Ser-49 appears during the S phase and G2, disappears rapidly in early mitosis during prometaphase, metaphase and early anaphase, and re-appears during telophase and cytokinesis.
相似性
Belongs to the Bcl-2 family.
功能
Potent inhibitor of cell death. Inhibits activation of caspases (By similarity). Appears to regulate cell death by blocking the voltage-dependent anion channnel (VDAC) by binding to it and preventing the release of the caspase activator, CYC1, from the mitochondrial membrane.
Isoform Bcl-X(S) promotes apoptosis.
Isoform Bcl-X(S) promotes apoptosis.
同靶标产品
相关文献
提示: 发表研究结果有使用 bs-25848R 时请让我们知道,以便我们可以引用参考文章。作为回馈,资料提供者将获得我们送上的小礼品。